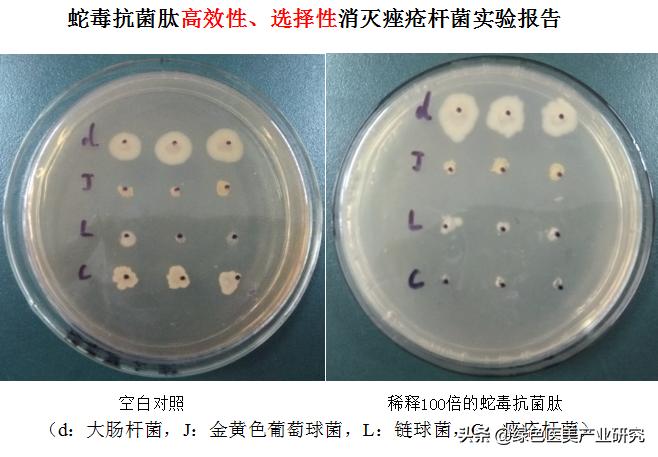
祛痘干货指南如何养成不长痘肤质,最全祛痘方法针对各种痘痘

对于一个爱美的妹纸来说,什么肌肤问题最不能忍呢,是肌肤干燥?是出油厉害?还是暗沉?都不是!
而是长痘痘!

痘痘是怎样形成的?
一张图看懂痘痘成因!

痘痘的成因有很多,主要是由于皮脂分泌过剩,堵塞了毛孔,皮肤垃圾无法及时排出,加上细菌感染发炎形成痘痘!
虽然说长痘痘有很多原因,但是直接引发长痘的,是皮肤中的细菌感染发炎导致的!
所以,想要消灭痘痘,那就得从灭菌方面着手才行。
在这里,不得不提一种常见的导致痘痘形成的细菌——*疮痤**杆菌。

*疮痤**杆菌
*疮痤**杆菌,它是一种本身存在我们身体里的一种细菌。其实每个人的毛囊里都有*疮痤**杆菌,它以皮脂为食,产生脂肪酸。在正常条件下,也就是我们皮肤中的有益菌和有害菌保持在一个相对平衡的状态下,*疮痤**杆菌可以帮助维持角质层的弱酸性环境,抵挡外来病原菌的入侵。
但是如果皮肤里的有益菌减少了,那*疮痤**杆菌就会过度繁殖,进而就会刺激毛囊引起炎性*疮痤**,也就会产生痘痘。
面对反反复复的痘痘,很多妹纸为了快速祛痘而选择了激素类祛痘产品,但这其实是饮鸩止渴,到最后痘没去成,反而破坏了皮肤稳定性,造成了不可逆的伤害。所以,想要祛痘干净彻底,还得从抑菌方面着手才算真正把痘去掉。
现在市面上很多祛痘产品最大的特点是控油,有些产品甚至只是使痘痘暂时性萎缩,并没有缓解痘痘中的炎症,平衡痘痘患处的微生物数量,所以导致痘痘反反复复。可以说是“痘痘挤不尽,春风吹又生”

那今天绿*医色**美给大家带来一个潜心研发多年推出的重磅祛痘神器——蛇毒抗菌肽!
从此让你和痘痘是路人,战痘再也不是难事!

祛痘神奇成分——蛇毒抗菌肽!
让痘痘彻底瓦解,从根本上解决痘痘!
可能大家一听到这个名字会觉得害怕。蛇毒?蛇毒不是毒吗?怎么可以拿来祛痘?

那蛇毒抗菌肽又是什么?它对比其他祛痘产品有什么特色?它又厉害在什么地方?
大家别着急!听小编慢慢道来哈!
首先,蛇毒抗菌肽是从蛇毒中提取出来的一种新型抗菌肽。它的本质是一种抗菌活性多肽成分,安全无毒的,对皮肤无明显的刺激性和过敏性。它具有广谱杀菌抑菌的功能,对多种细菌有良好的杀菌抗菌作用,特别是针对*疮痤**杆菌有很强的灭菌效果。

下面,让我们一起来揭开这个神奇祛痘成分的神秘面纱!
蛇毒抗菌肽的灭菌作用原理:
蛇毒抗菌肽有非常强的识别功能,它很喜欢依附在*疮痤**杆菌的细胞膜上,并破坏细胞膜形成孔道,使细菌里的内容物流出,造成细菌死亡,从而达到灭菌的作用。

蛇毒抗菌肽灭菌实验
可能大家在这里会想到一个问题——既然这个蛇毒抗菌肽是抗菌灭菌功效的,那长期使用会不会形成耐药性?
在这里,我给大家说一说这个蛇毒抗菌肽的强大之处!
由于蛇毒抗菌肽是让细菌细胞膜形成孔道,就像身体有个窟窿失血过多导致死亡的一样,因此这些细菌也难以产生耐药性,相对于以前在祛痘产品中添加抗生素更加安全(PS:长期使用抗生素会让*疮痤**杆菌形成耐药性,还会造成激素脸),不用担心激素脸的产生,可以放心的去战痘咯!

那可能大家会问,既然这个蛇毒抗菌肽杀菌能力这么强,那会不会同时也把我们皮肤里其他的有益菌也消灭了,造成其他皮肤问题?
下面我们先来看一组蛇毒抗菌肽灭菌实验报告:
蛇毒抗菌肽灭菌实验
在上图的实验中,培养皿中一共含有4种细菌,其中“C”为*疮痤**杆菌,当把稀释100倍的蛇毒抗菌肽加入到培养皿中后,标志为“C”的*疮痤**杆菌的白色部分(细菌大量繁殖而形成的白色块)显著减少,而其他细菌却几乎没改变
所以,从这组实验中,我们可以看得出,蛇毒抗菌肽对*疮痤**杆菌有强效的选择性杀灭作用,并不会对其他细菌造成伤害。因此,在使用蛇毒抗菌肽祛痘的时候,它不会对皮肤中其他有益菌造成伤害,不会产生其他副作用。

另外呢,蛇毒抗菌肽不仅能够高效选择性灭菌,它还含有少量水解脂类的酶,可以改善*疮痤**患者的皮脂代谢,同时具有显著的抗炎作用,对各种皮肤的炎症和过敏反应都有抑制改善作用。
所以,用蛇毒抗菌肽祛痘,不仅高效,还不留后患!真正从痘痘的根本解决问题,做到根源祛痘,绿色祛痘,并还你一个无痘光滑的健康肌肤。

绿*医色**美出品,必属精品!
全新抗痘精品,敬请关注!